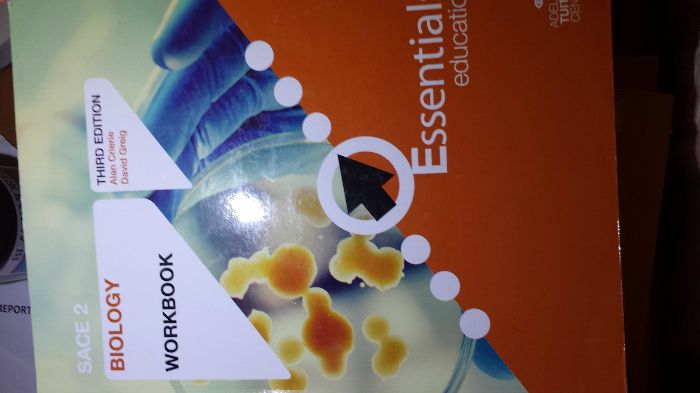
������Ǯ15�� ����work book����saceָ����ϰ�ᣬÿһ�¶�����ϸ��������ϵ

本内容为网友发布信息,仅代表原作者观点,不代表本平台立场。
-
单本价钱30刀 普数书

-
单本价钱10刀 2014普数revision guide往年考试题与专章复习

-
单本价钱30刀 高数书

-
单本价钱15刀 生物work book属于sace指定练习册,每一章都有详细讲解与联系
-
单本价钱25刀 生物课本,对于英语非母语的人来说看透这本教科书生物就没什么问题了

-
单本价钱30刀 推荐化学教科书之一,特点是详细的分析与解释每一个知识点

-
单本价钱15刀 化学revision guide往年考试题与专章复习。后面的答案把每一个得分点都说得特别明白。

-
单本价钱10刀 高数revision guide往年的考试题和专章复习

-
单本价钱15刀 生物revision guide往年考试题与专章复习。答案解释得很明白,即使是选择也把每一个选项都分 ...

-
单本价钱35刀 推荐化学教科书之二。详细的推理过程与提供相对应每个知识点的练习题

BBS提醒: 请避免提前支付订金、押金等任何费用,请与对方当面沟通,确认资质并看清条款。谨防上当受骗。
免责声明: 本网站所提供的信息,只供参考之用。本网站不保证信息的准确性、有效性、及时性和完整性。本网站及其雇员一概毋须以任何方式就任何信息传递或传送的失误、不准确或错误,对用户或任何其他人士负任何直接或间接责任。在法律允许的范围内,本网站在此声明,不承担用户或任何人士就使用或未能使用本网站所提供的信息或任何链接所引致的任何直接、间接、附带、从属、特殊、惩罚性或惩戒性的损害赔偿。